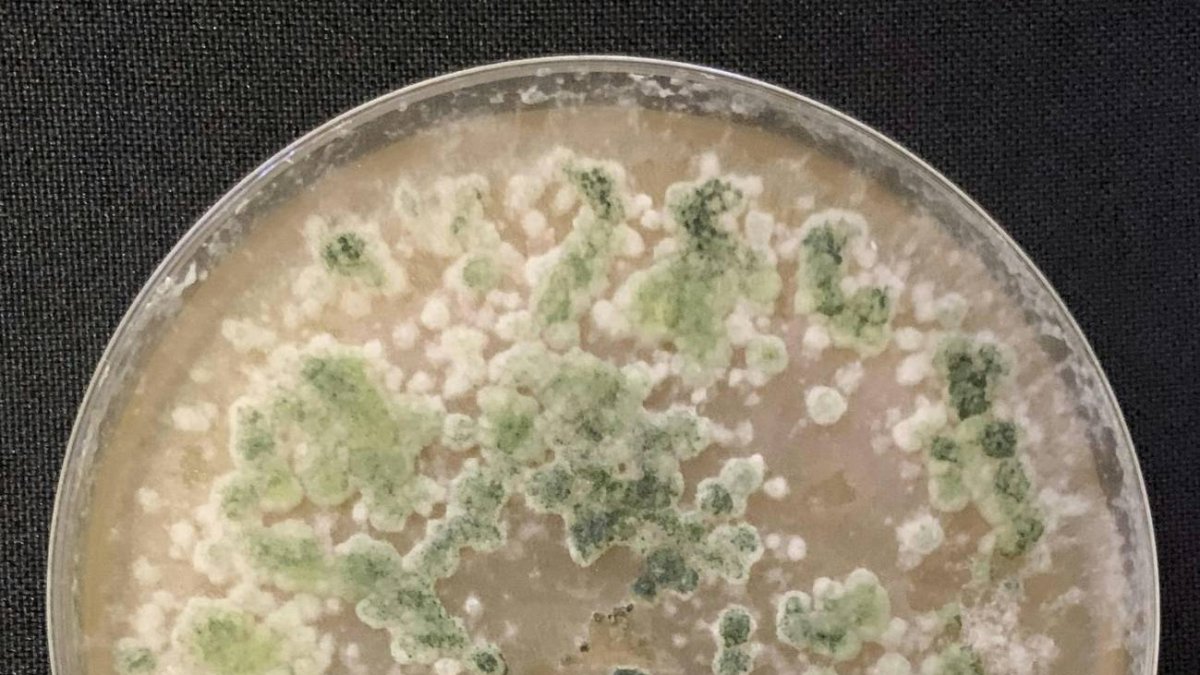
Trichorderma se reconoce muy fácilmente en la placa Petri porque es muy particular, de color muy verde y con una gran plasticidad morfológica. / L

Hongo ‘prodigio’ para salvar los bananos mexicanos y otros cultivos comerciales
El género de hongo Trichoderma, presente en todo el mundo, ha demostrado ser muy beneficioso
Trichorderma se reconoce muy fácilmente en la placa Petri porque es muy particular, de color muy verde y con una gran plasticidad morfológica. / L
Una epidemia de dimensiones equivalentes a la provocada por la covid-19 en humanos se propagó globalmente en la primera mitad del siglo XIX entre las poblaciones de banano. La enfermedad de Panamá, causada por el hongo Fusarium oxysporum, responsable de centenares de infecciones en otras especies vegetales, se cebó con los cultivos de algunas regiones tropicales, golpeando con más ahínco a Latinoamérica.
Probablemente originada en el sureste asiático, el primer registro de la infección se realizó en Australia en 1874 y, casi 20 años después, fue reportada en Panamá.
“En los noventa, otro gran brote azotó las plantaciones de Centroamérica, extendiéndose hasta África y Asia”, explica Luis Maldonado, investigador de la Universidad del Mar (UMAR) y experto en este patógeno cuya dispersión sigue presentando una gran amenaza para los bananos, su principal hospedador. “Ahora mismo está devastando platanares en Australia, hay reportes en Colombia y Perú, e incluso ha llegado a un jardín botánico en Inglaterra”, expone el biólogo molecular.
México todavía no ha registrado ningún brote, pero sus científicos están en alerta. “El cultivo de plátano tiene una amplia distribución en el país, es uno de sus principales productos de exportación”, cuenta Maldonado, que empezó en el 2019 a investigar métodos para prevenir un ataque fúngico. “El cultivo de banano tiene una gran importancia para la población de esta región”, matiza el biólogo de la UMAR, centro de investigación situado en la costa de Oaxaca, estado al sur del país.
La solución que llega del propio reino Fungi
Ante la posible llegada de la enfermedad de Panamá a territorio mexicano, Maldonado y su equipo estudian otro hongo como método preventivo. De carácter cosmopolita, el género Trichoderma cuenta con una larga lista de especies beneficiosas para combatir patógenos en cultivos. “La primera evidencia de su potencial como biocontrolador data desde el año 1932”, cuenta el biólogo.
Como explica Indira Rojo Báez, investigadora de la Facultad de Biología de la Universidad Autónoma de Sinaloa, “este tipo de hongos se encuentran en una gran variedad de hábitats y tipos de suelo, en materia orgánica e inorgánica, incluso como organismos endófitos”, aquellos que habitan en el interior de las plantas. “Son claves para la agricultura por sus habilidades antagonistas, fácil manipulación y ubicuidad”, agrega la especialista, autora de un trabajo sobre la diversidad del hongo y su potencial de utilización en la agricultura mexicana. De acuerdo con su estudio, publicado recientemente, México cuenta con hasta 42 especies reportadas de las 375 especies estimadas.
“Aunque T. asperellum y T. harzianum son los más destacados, muchos hongos del género resultan beneficiosos e indispensables para mantener los suelos en las condiciones ideales y combatir enfermedades en cultivos de interés comercial”, asegura Rojo.
Plantas ornamentales o árboles también se benefician
Las frutas, cereales y otros vegetales a los que Trichoderma brinda protección son múltiples. Destacan el arroz, maíz, trigo, cebada, garbanzo, algodón, cítricos, café, papa, cebolla, fresa, calabaza, melón, kiwi, chile, uva, lechuga, e incluso árboles forestales y plantas ornamentales. La lista es larga.
Diversos estudios han demostrado cómo este organismo eucariota contribuyó, por ejemplo, a una mejor protección de plantas de cacahuate en comparación con un fungicida artificial contra la infección conocida como El tizón del Sur. En plantas de tomate han conseguido reducir la formación de agallas y se ha estimulado la germinación de semillas de sorgo, un tipo de cereal de origen africano que se produce en América Latina para consumo humano y animal.
Entre otros muchos ejemplos de las competencias de la familia Trichoderma también se ha evidenciado su potencial biológico para controlar el desarrollo de antracnosis, una infección que perjudica a los mangos. Este producto ha posicionado a México como uno de los líderes mundiales en exportación, junto al banano, el cultivo que quiere salvar Maldonado desde su laboratorio frente al océano Pacífico.
En 2021, su equipo consiguió aislar de una planta de plátano manzano una cepa de T. harzianum con capacidad antagonista sobre los hongos causales de su amenaza más grave, la enfermedad de Panamá. “La especie fue identificada a través de observaciones de microscopía óptica y secuenciación. Trichorderma se reconoce muy fácilmente en la placa Petri porque es muy particular, de color muy verde y con una gran plasticidad morfológica”, asegura el biólogo.
Mecanismos de supervivencia
Una característica muy notable de este tipo de organismo “es que produce de forma salvaje sus esporas. Sus conidios —estructura de protección y de dispersión hacia nuevos hábitats—, son óptimos para hacer preparaciones que luego se dispersan en el campo”, destaca Maldonado. Esto facilita la elaboración de formulaciones de control biológico que contribuyan a producir plantas libres de patógenos y frutos sanos de alta calidad.
Según Rojo, el éxito de Trichoderma radica en su capacidad de desarrollar mecanismos de sobrevivencia y proliferación, “que incluyen la habilidad de atacar o inhibir el crecimiento de otros hongos mediante la producción de enzimas hidrolíticas que degradan carbohidratos complejos”. Por selección natural estos organismos han desarrollado armas para atacar otros hongos patógenos. “No es que sean villanos, su objetivo es defenderse y perpetuarse en el ambiente”, matiza Maldonado.
Además de su función biocontroladora, se pueden utilizar para otros menesteres, como la producción de biofertilizantes. Al interaccionar con la rizosfera vegetal, el ecosistema del suelo próxima a las raíces, promueven el desarrollo de plantas mediante factores de crecimiento, disminución del pH del suelo y brindando protección contra químicos tóxicos.
Como los organismos oportunistas que son, también proveen una respuesta sistémica, “pueden hacer llegar a las hojas de las plantas señales que las fortalecen y vacunan en caso de que aparezca una bacteria o patógeno”, explica Maldonado. E incluso pueden disminuir la contaminación del suelo agrícola al fomentar la recuperación de forma natural de ambientes alterados, un proceso conocido como biorremediación.
En el Estado de Hidalgo, por ejemplo, se utilizaron cepas nativas de Trichoderma para paliar la contaminación por atrazina, herbicida de uso generalizado. Aunque el hongo milagro consiguió degradar el 89 % del químico en 40 días, como explica Rojo, “hasta el momento no se tiene conocimiento sobre su comercialización para este fin en México”.
Existen ya diversos laboratorios comercializadores de Trichoderma para el control biológico. T. harzianum destaca como la especie principalmente comercializada y Sinaloa como el principal estado productor. No obstante, dado los beneficios al medio ambiente y en la mejora de la calidad de los cultivos que ha demostrado, podría ser mucho más explotado.
Un género difícil de diferenciar
La identificación morfológica en especies de Trichoderma por sí sola es difícil. “En México se realiza complementando la identificación morfológica con la identificación molecular”, apunta la especialista de la Universidad de Sinaloa.
Los estudios realizados en este país han utilizado hasta tres regiones génicas para discernir entre las distintas especies. “Es necesario aumentar el número de biomarcadores basados en regiones variables del genoma para aumentar la robustez del poder discriminatorio en la identificación molecular. Y de esa forma promover la agricultura sustentable”, concluye Rojo.
Hasta la fecha se desconocen iniciativas gubernamentales o privadas que exploten los resultados obtenidos en ensayos. “Son escasos los trabajos que aplican especies de este hongo a gran escala en el campo agrícola, falta mucha difusión”, opina la especialista.
Cada año se publican nuevos reportes sobre su identificación morfológica y molecular. “Pero muchas veces no se tienen identificadas aquellas con beneficios en la elaboración de productos orgánicos, por ejemplo”, concluye, a la vez que lamenta que la agricultura mexicana esté perdiendo la oportunidad de aprovechar las bonanzas de este hongo prodigio.
Fuente: SINC